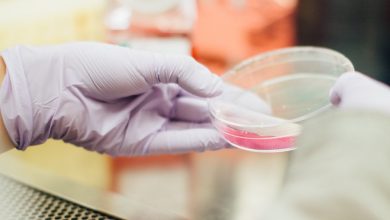

Pentagon
-

-

-
 28 mei 2026 17:0022
28 mei 2026 17:0022Mysterie groeit: Generaal had vlak voor hij vermist raakte geheime UFO-meeting
-

-
 9 mei 2026 06:00117
9 mei 2026 06:00117UFO-waarnemingen Apollo-astronauten: wat verzwegen NASA-dossiers onthullen
-
 8 mei 2026 20:2538
8 mei 2026 20:2538UFO-files Pentagon vrijgegeven: wat verbergen ze echt?
-

-
 12 november 2025 10:3045
12 november 2025 10:3045Verontrustend: Onder Kennedy gaan de gruwelijke experimenten met honden gewoon door
-

-

-

-

-
 8 december 2024 12:0082
8 december 2024 12:0082Kijk: Dit zei oud-generaal Wesley Clark in 2007 over het lot van Syrië
-
 18 november 2024 19:0055
18 november 2024 19:0055‘Waren het meerdere soorten wezens?’ Congreslid bevraagt getuige over lichamen in bezit van Defensie
-
 29 oktober 2024 09:3091
29 oktober 2024 09:3091Kennedy onthult door wie de COVID-19-vaccins werkelijk zijn gemaakt (nee, niet door Pfizer)
-

-

-

-

-
 11 september 2023 14:0060
11 september 2023 14:0060Deze fabelachtige voorspelling is met stip de meest opzienbarende gebeurtenis rondom 9/11
-
 25 augustus 2023 18:0044
25 augustus 2023 18:0044Pepijn van Houwelingen roept AIVD op: ‘Complottheorie! Dat mag niet! Doe er wat aan!’
-
 12 augustus 2023 15:0061
12 augustus 2023 15:0061Miljoenen weten nu wat er echt gebeurd is: ‘Dit is ongelooflijk schokkend, dit was opzet’
-
 22 juli 2023 21:00108
22 juli 2023 21:00108‘Wow, ongelooflijk’: schokkende cijfers over de oorlog in Oekraïne
-

-
 14 juni 2023 06:00128
14 juni 2023 06:00128UFO-klokkenluider beweert dat ‘niet-menselijke intelligenties’ mensen hebben gedood
-
 14 april 2023 14:30105
14 april 2023 14:30105Tucker Carlson doet boekje open over UFO’s: hier komen ze vandaan
-

-
 14 maart 2023 18:00196
14 maart 2023 18:00196Officieel overheidsrapport: mogelijk buitenaards moederschip in ons zonnestelsel
-

-
 22 februari 2023 14:0096
22 februari 2023 14:0096Veteranen getuigen hoe mysterieuze objecten kernraketten uitschakelen
-
 13 februari 2023 11:25141
13 februari 2023 11:25141Dit zei een Amerikaans congreslid over UFO-wrakstukken die geborgen zijn
-
 6 februari 2023 21:45107
6 februari 2023 21:45107Russen vinden ruim 20.000 documenten over biolabs in Oekraïne, dit staat erin
-
 17 mei 2022 18:0072
17 mei 2022 18:0072Historische hoorzitting: ‘Geheim genootschap in Pentagon verbergt UFO-geheimen’
-

-
 8 maart 2022 21:3590
8 maart 2022 21:3590Wat hebben Biden, Klaus Schwab & CIA te maken met Amerikaanse biolabs in Oekraïne?
-
 8 maart 2022 16:3049
8 maart 2022 16:3049Russische leger zegt meer dan 30 Amerikaanse biolabs te hebben gevonden in Oekraïne
-
2 maart 2022 21:4530
2 maart 2022 21:4530Russische ambassade: ‘Amerika zet Oekraïne vol met biolabs’



